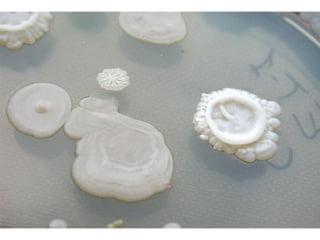
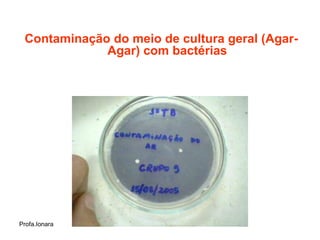
Contaminação do meio de cultura geral (Agar-
             Agar) com bactérias




Profa.Ionara

O documento resume as principais características dos reinos Monera e Archaea, com foco nas bactérias. Discorre sobre a estrutura, reprodução, diversidade metabólica e importância ecológica e biotecnológica das bactérias. Também aborda processos como a transformação, transdução e conjugação genética em bactérias, além do ciclo do nitrogênio e do uso de bactérias na biotecnologia.